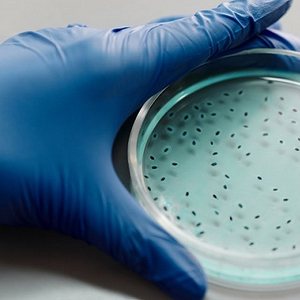

原标题:发令枪响,肠道菌群产业何时加速领跑?
来源:火石创造

图片来源:Pexels-Edward Jenner
“六经为川,肠胃为海。”——《黄帝内经·素问·阴阳应象大论篇第五》
古语借自然事物类比人体组织,是中医天人合一、和谐共生理念的体现。那么在现代医学的视野中,人体微生态系统与机体的共生关系似乎从另一角度也印证着这种和谐平衡的理念。
随着生命科学研究的发展,人体微生态系统与健康、疾病的关系开始得到揭露,二者之间存在着一种动态平衡:平衡-健康,失衡-致病。
肠道菌群:守护人体健康的骑士与风向标
在人体微生态系统中,肠道微生物是最庞大、最复杂的一个,其中的细菌可分为有益菌、有害菌和中性菌。在健康状况良好的情况下,有益菌占比最大,有益菌菌群对宿主发挥着重要的生理功能。
肠内有益菌菌群占优势,表示肠内环境好。一方面,对于身体的代谢来说,有益菌菌群可以促进排泄和排出有害物质;另一方面,它可以提高身体的免疫机能,抑制病原菌的侵害。此外,有益菌还可以促进人体营养吸收和生成人体所需的一些营养物质。
反之,当肠道菌群的结构失衡,将对人体健康产生消极影响。大量研究表明,肠道菌群与一些疾病之间存在联系,包括消化道疾病、代谢类疾病、免疫性疾病以及精神疾病等,目前已有研究发现的关联情况如下。

正是由于肠道菌群和疾病之间有着密切关系,对肠道菌群检测成为检查人体健康状况的重要途径。
得益于基因测序技术的发展,肠道微生态研究在几年前就已经成为生命科学研究的热点。在更早时候,欧美就相继展开了相应的研究计划。美国在2007年便启动了人类微生物组计划(HMP),欧盟也在2008年启动人类肠道宏基因组计划(MetaHIT),2016年美国再次启动国家微生物组计划(NMI)。
肠道微生态研究也逐渐进入我国的规划中。2016年,包括中国科学院微生物研究所在内的17家单位共同参与了十三五重点研发计划《益生菌健康功能与基于肠道微生物组学的食品营养代谢机理研究》;2017年中国科学院微生物组计划启动。后续多项与肠道微生态相关的研究也陆续展开。
肠道微生态的科研进展,势必带动肠道菌群产业的发展。那么本文将梳理我国肠道菌群领域相关企业发展状况,来探究肠道菌群产业在大健康产业中的发展。
入局者不断,一点多面的业务布局渐完善
以肠道菌群(肠道微生态)为关键词,本文全统计了22家布局肠道菌群业务的企业,汇总如下表。
围绕肠道菌群的业务布局,益生菌等已经在食品和营养市场上被广泛应用,本文对此不做更多的介绍,我们主要关注检测和治疗两个大方向。
在检测方面,国内的企业主要集中于肠道菌群检测和健康管理。在治疗方面,有提供粪菌移植(FMT)相关服务和创新药物研发。以下我们将从这22家企业的业务布局特点、分布地区和融资情况等方面,来探究肠道菌群领域的企业布局特点。
1、偏重菌群检测服务,打造检测+干预闭环
由上表可知这些企业主要是基因检测公司、生物医药公司和结合基因检测技术和治疗方案开发的生物科技公司三类。那么依据这22家企业提供的产品和服务的不同,对其业务进行进一步分类,可以划分为药物研发、健康管理、食品开发、肠道菌群检测、菌群移植和其他(提供科研技术服务等)6类,分布如下图。

首先,总的来看企业的业务分布较为广泛,涵盖了制药、菌群移植、基因检测等多个领域,但集中于肠道菌群检测。由上图可知提供肠道菌群检测服务的企业是最多的,15家占比约68%。其次是健康管理和食品开发,各有9家企业提供。然后从高至低依次是药物研发、菌群移植和其他服务类型。
为什么提供检测服务的企业这么多?一方面,得益于基因测序技术的发展成熟。对肠道微生物的检测没有过高的技术壁垒,企业较容易进入。
另一方面,相较于生物制药和菌群移植,检测服务所需要承担的成本和风险更可控。活菌药物开发时间长、投入大;菌群移植作为一种医疗技术标准尚未统一,治疗效果也难以得到稳定保证。加之国内对于活菌药物和菌群移植的管理条例还没有完全明确。因此对于企业来说,检测服务是一个进可攻,退可守的好选择。
其次,除部分基因检测企业和生物制药企业专注于单一业务之外,多数企业提供复合多样化的服务。表格中超一半的企业提供复合型服务。尤为突出的是提供肠道菌群检测的企业,往往会同时提供健康管理服务,即针对菌群检测结果给出分析建议和制定相应健康管理方案,帮助用户调整肠道菌群,维护肠道健康。
例如普瑞森基因,在肠道菌群基因检测后,通过生物信息学分析粪便微生物的组成为用户提供疾病风险及健康建议,同时针对三高人群提供包含益生菌、益生元及饮食在内的健康管理方案。
健康管理成为企业核心业务之外的重要拓展方向,得益于肠道菌群可干预的特点。华大生命科学研究院研究员李俊桦在公开演讲中说:“相较于基因组,我们的肠道菌群,它有可干预的特点,这使得它在大健康应用方面有独特的优势。”基于这一点,肠道菌群领域的企业可以根据“检测+干预”的商业闭环模式,基于自己的核心业务延展服务和产品线,找到更多应用落地的机会。
还有的企业希望打造一个一体化的服务平台。其中,善行生物以肠道菌群为核心开发产业化项目,包括肠道微生态菌群测序、肠道微生态移植临床应用、便便银行收储、肠道微生态胶囊制备、个性化益生菌定制等。
承葛生物则依托精准化菌群移植治疗平台(PMTT)和微生态药物的研发,构建以肠道微生态为靶点的疾病预防、诊断、疗法及愈后评估、营养指导等一体化综合服务平台,提供精准化菌群移植整体解决方案,实现全生命周期的健康管理。
2、新玩家不断,治疗领域逐渐升温
在蓝色彩虹关于肠道微生物产业的文章中说过:“人体微生物要真正实现产业化,仅仅做检测产品是远远不够的。”企业需形成“检测+干预”的商业闭环,才能驱动产业有机发展。其实,除了上文所说的健康管理,治疗也是干预环节中重要的一部分。
从本文统计的22家企业来看,新企业不断地进入肠道菌群产业领域。其中,2018年到2020年成立的4家企业,分别是善行生物、一兮生物、和度生物和浩鼎瑞,其主要布局治疗,提供药物研发或肠道菌群移植等相关业务。
在药物研发方面,除了上述新企业布局外,还有奕景生物、未知君、承葛生物、知易生物、慕恩生物等共7家企业。其中,部分企业其药物研发进展如下。

在肠道菌群移植方面,粪菌移植主要作为一种医疗手段在医院中完成,企业能够提供的服务主要是粪菌库和菌群配型等。本文统计企业中,有微健康基因、善行生物、浩鼎瑞、承葛生物等4家企业有提供菌群移植相关服务。
其中,承葛生物建立了精准化菌群移植治疗平台(PMTT),包括通过供体筛选、菌群分离提取、菌群库建设、供受体配型、菌群移植方式(菌液、胶囊)、移植疗效维持6个板块。
目前,承葛生物已经建成华南菌群库、海峡菌群库、苏州菌群库,未来计划建立八大核心区域菌群库,为医院实施菌群移植提供支持。此外,该企业还提供粪便分析前处理仪及耗材、定制菌群和定制菌液、微生态食品等产品。
微健康基因主要针对儿童提供粪菌移植配型和评估;善行生物提供粪菌储存业务和肠道菌群样品标准化制备和移植;浩鼎瑞(东源益康)提供肠菌液和肠菌胶囊产品。关于肠菌胶囊和肠菌液,它们是肠菌移植所需的健康肠菌最终的制剂形态,前者可通过口服方式实现菌群移植,后者则主要通过鼻肠管、无痛胃镜、内镜肠道置管实现菌群移植。
3、集中分布于东部地区,广东最突出
根据本文的统计数据来看,企业集中在东部地区,主要分布于广州、深圳、上海等中心城市。这主要得益于东部中心城市的资本吸力大、政策开放度高以及拥有高校、医院等科研和临床力量的支持。

以广州为例,2018年广州市发改委审批通过了菌群移植,使其有了正式的收费编码。此后不久,菌群移植技术又获得广东省医保局的批文。对此,承葛生物创始人说:“这是中国菌群移植这个行业中,将菌群移植定义为医疗新技术的一个里程碑事件,因为它同时具备了菌液制备以及菌群移植技术两条收费编码。“
资本关注,肠道菌群产业何时引领风尚?
2020年8月,Seres Therapeutics 公司宣布旗下肠道微生物组药物SER-109的3期临床试验结果,表明SER-109可有效减少艰难梭菌复发风险。Seres Therapeutics 公司股价当日应声暴涨近400%,股价超过20美元。
一方面,随着越来越多研究发现的公布,资本对微生物疗法寄予厚望。另一方面,得益于国家政策对微生物研究及产业发展的支持和科普的推进,肠道菌群已经开始走向大众生活。未来,肠道菌群领域势必会加快产业化进程。
资本不代表一切,却是市场潜力的有力佐证。总体来看,资本比较关注该肠道菌群产业的发展。在本文的统计中,超三分之二的企业都获得了融资。
从融资轮次来看,先发优势初步凸显。获得A轮及A轮之后融资的企业,集中在2014年前后成立,最晚2017年成立。相较于后成立的企业,先发者不仅在自己的业务范围内已经有了较为成熟的产品和服务,而且还在拓展中,因此更受资本青睐。

从最新融资时间和金额来看,近两年发生在肠道菌群领域的投资频繁,且金额较大。在本文统计的企业中,从2019年6月到2021年6月的两年中,有11家企业获得了融资。其中,知易生物一家企业获得了过亿的融资;还有5家企业的融资金额处于千万级,分别是未知君、承葛生物、零一生命、慕恩生物、一兮生物。
虽然资本看好,但总体而言,我国的肠道菌群产业发展还处于早期,还需要更多培育时间。
对于企业来说,现有的产品和服务较为单一,商业模式有待进一步发展完善。如企业在打造检测+干预闭环时,产业化开发不足。虽然多数企业意识到了商业闭环的重要性,但大部分企业提供的干预手段单一,主要集中于益生菌产品上,且中短期内很难看到干预效果。
对于市场来说,肠道菌群产业面对的是一个没有完全觉醒的庞大消费市场,还需要进一步的市场教育。
人体微生物研究的进展打响了肠道菌群产业起跑的信号,领跑前列固然值得期待,但这是一场不必急于一时的长跑。赛道上的成绩如何,需要看下的功夫有多深。
参考资料:
[1] 苗先锋. 肠道微生态产业发展现状分析. 火石创造. 2019-09.
[2] 戴名菡. 肠道微生物产业被看好,国内外布局差别大. 蓝色彩虹. 2018-12.
[3] 戴名菡. 产业发展遇阻力,形成干预是关键. 蓝色彩虹. 2019-03-29.
[4] 肖传兴:中国菌群移植产业化的机遇、监管和前景. 热心肠先生. 2020-06-28.
[5] 焦艳丽. 2款重磅药物即将进入临床,慕恩生物如何打赢全球微生物疗法军备竞赛?. 动脉网. 2021-04-07.
[6] 李俊桦:22分钟详解打开肠道产业的“毒·药”钥匙. 热心肠研究院. 2020-09-28.
[7] 重磅发布:2020-2021肠道产业十大事件. 热心肠研究院. 2021-06-02.